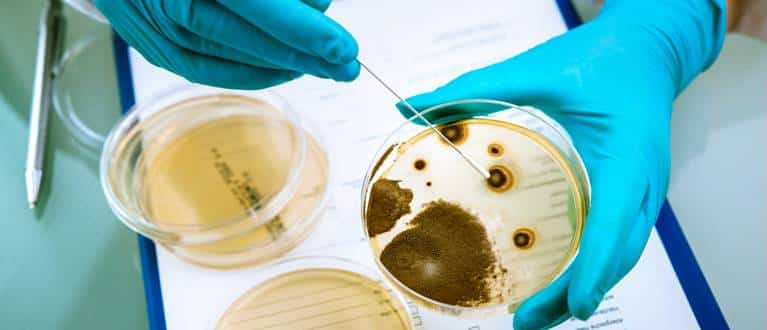
Listeriosi: coltura su agar

Se hai un abbonamento attivo ACCEDI QUI
Listeriosi: incubazione, trasmissione e profilassi
Listeriosi: scheda riassuntiva di notifica e profilassi
Classificazione ICD-9: 027.0
Tipo di Notifica: Classe II
Periodo di incubazione: Abitualmente tre settimane, ma può variare da 3 a 70 giorni dopo esposizione o consumo di un prodotto contaminato.
Periodo di contagiosità: La Listeria può essere presente per mesi nelle feci di individui infetti.
Nelle madri di neonati affetti da listeriosi connatale può essere riscontrata nelle secrezioni vaginali e nelle urine per 7-10 giorni dopo il parto.
Provvedimenti nei confronti del malato: Non sono necessarie misure di isolamento1; sufficiente il rispetto delle comuni norme igieniche e di precauzioni enteriche2.
Provvedimenti nei confronti dei conviventi e dei contatti: Ricerca attiva della sorgente di infezione e dei soggetti eventualmente esposti.
Sorveglianza sanitaria3 per identificare possibili focolai epidemici con ricerca della fonte comune di infezione/esposizione.
Raccomandazioni circa l’astensione dal consumo di carni crude e poco cotte e di latte non pastorizzato e prodotti derivati, per le donne in stato di gravidanza e per le persone con alterazioni dell’immunocompetenza.
2 Precauzioni enteriche: uso di guanti nel caso di manipolazione o contatto con materiali contaminati e uso di grembiuli in caso di possibilità di insudiciamento, per prevenire la trasmissione di infezioni trasmesse per mezzo del contatto diretto o indiretto con le feci. Una stanza ed un bagno separati sono indicati nel caso di scarsa igiene del paziente
3 Sorveglianza sanitaria: obbligo di sottoporsi a controlli da parte dell’Autorità sanitaria, senza restrizione dei movimenti, per un periodo di tempo pari a quello massimo di incubazione della malattia
Generalità
Le Listeriosi cono un gruppo eterogeneo di patologie causate da Listeria monocytogenes, un bacillo Gram-positivo che può essere isolato dal terreno, da fonti vegetali e da molti animali.
Sono tipicamente colpiti pazienti immunocompromessi o donne in gravidanza.
Una quota sostanziale delle listeriosi umane è legata alla trasmissione alimentare di Listeria monocytogenes.
A differenza della maggior parte dei patogeni trasmessi con il cibo che causano primariamente malattie gastrointestinali, Listeria monocytogenes dà luogo a sindromi invasive quali meningite, setticemia, corioamnionite e morte fetale.
Eziologia
La Listeria è un bacillo aerobio o anaerobio facoltativo, non sporigeno, che cresce bene a temperature comprese tra 1 e 45 °C e che possiede una caratteristica motilità “a capriola” quando coltivato a 20-25 °C.
Le caratteristiche che differenziano Listeria monocytogenes dalle altre specie di Listeria sono la produzione di una zona circoscritta di β-emolisi su agar sangue di pecora e la fermentazione di glucosio, maltosio, L-ramnosio e α-metil-D-mannoside, ma non di D-xilosio.
La determinazione del sierotipo di Listeria monocytogenes è basata sugli antigeni somatico (O) e flagellare (H).
Nell’uomo la maggior parte dei casi di malattia è causala dai sierotipi l/2a, l/2b e 4b.
Patogenesi delle Listeriosi
Listeria monocytogenes è un patogeno intracellulare con tendenza a causare malattia in soggetti con deficit dell’immunità cellulo-mediata.
Il microrganismo è presente nella normale flora gastrointestinale degli individui sani.
Una diminuzione dell’acidità gastrica e un’alterata funzionalità gastrointestinale possono aumentare il rischio di malattia invasiva a seguito di un’esposizione al microrganismo a livello del tratto gastrointestinale.
L’aumentato rischio di infezione da Listeria monocytogenes che si osserva nelle donne in gravidanza può essere dovuto a modificazioni immunologiche sia locali sia sistemiche associate alla gravidanza.
Per esempio, l’immunosoppressione locale a livello dell’interfaccia malerno-fetale della placenta può favorire l’infezione intrauterina in seguito a una transitoria batteriemia materna.
La patogenesi molecolare dell’infezione da Listeria monocytogenes è stata chiarita di recente.
La proteina di superficie internalina interagisce con recettori specifici inducendo la fagocitosi.
Sia la listeriolisina O sia la fosfolipasi permettono al microrganismo di fuoriuscire dai fagosomi verso il citosol e di evitare così l’uccisione intracellulare.
Attraverso la proteina di superficie Act A, Listeria monocytogenes sfrutta dei movimenti actina-mediati per spostarsi verso la membrana cellulare.
Un’efficiente diffusione da cellula a cellula è portata a compimento sia dalla formazione di filamenti di actina, sia dalla produzione di fosfolipasi.
I determinanti genetici di queste proteine sono stati caratterizzati.
Poiché il microrganismo è adattato sia alla vita intracellulare sia alla diffusione diretta da cellula a cellula, esso non viene eliminato dagli anticorpi.
Epidemiologia della Listeriosi
Listeria monocytogenes, da lungo tempo riconosciuta come patogeno negli animali, causa meningite della base e morte fetale nelle pecore e nei bovini.
L’incidenza della listeriosi nell’uomo è divenuta oggetto di crescente attenzione grazie al riconoscimento del ruolo dei cibi contaminati nella patogenesi della listeriosi epidemica e all’aumento delle segnalazioni di malattia associato all’espansione della popolazione immunosoppressa.
La sorveglianza dei casi sporadici di listeriosi condotta in diversi Paesi indica che il 20% delle infezioni è fatale o provoca la nascita di un feto morto, sebbene siano stati osservati tassi di letalità più elevati in corso di epidemie di listeriosi e in casistiche precedenti.
La maggior parte dei casi di malattia dovuti a Listeria monocytogenes è sporadica; lo studio di diverse epidemie di listeriosi verificatesi durante gli anni ’80 e gli anni ’90 ha dimostrato, tuttavia, che la trasmissione attraverso una fonte alimentare è la causa della malattia nell’uomo e che il periodo di incubazione in seguito al consumo di cibo contaminato può essere di 2-6 settimane.
L’epidemia più ampia del Nord America, che si è verificata a Los Angeles nel 1985, ha interessato più di 100 persone e ha determinato 48 casi a prognosi infausta, tra decessi e aborti.
Un’epidemia su scala nazionale in Francia nel 1992 ha interessato 279 soggetti e ha causato 63 decessi.
I cibi implicati nelle epidemie di listeriosi comprendono insalate con cavoli contaminati, latte pastorizzato, formaggi teneri, paté, prodotti di carne suina insaccati e hot dog.
Studi epidemiologici hanno suggerito un ruolo anche del pollo poco cotto, di hot dog non cotti, formaggi teneri e, in casi sporadici, di alimenti di alta gastronomia.

La contaminazione dei cibi da parte di Listeria è relativamente frequente.
Tra gli alimenti contaminati dal microrganismo, quelli pronti per il consumo sono contaminati a livelli elevati con il sierotipo 4b e sono i più pericolosi.
Il lungo periodo di incubazione della listeriosi contribuisce alla difficoltà di individuare lo specifico alimento all’origine sia delle epidemie che dei casi sporadici.
Anche se si ritiene che la trasmissione con il cibo sia la principale causa della malattia epidemica e sporadica, diversi episodi di infezioni neonatali tardive suggeriscono che si può verificare una trasmissione nosocomiale di Listeria monocytogenes.
Materiali e apparecchiature multiuso contaminati sono stati considerati responsabili di alcune ristrette epidemie nosocomiali.
La listeriosi è stata descritta nei veterinari e in altri soggetti a stretto contatto con animali infetti.
Listeriosi: quadro clinico
La listeriosi associata alla gravidanza si può verificare in qualsiasi periodo, anche se la maggior parte delle infezioni viene diagnosticata nel terzo trimestre, forse perché non vengono eseguite colture batteriche nei casi di aborto e morte fetale che si verificano più precocemente.
Dalla metà ai due terzi delle gravide con listeriosi perinatale mostrano una lieve malattia caratterizzata da febbre, mialgie, malessere e dolori lombari, a volte accompagnati da diarrea, dolore addominale, nausea e/o vomito durante la fase batteriemica.
Le emocolture sono diagnostiche.
La diffusione transplacentare del microrganismo comporta un’infezione intrauterina, che può condurre a corioamnionite, parto prematuro, morte fetale intrauterina o infezione precoce del neonato.
Le donne con listeriosi diagnosticata in gravidanza hanno una prognosi favorevole dopo la terapia antibiotica o il parto.
Anche se deve essere presa in considerazione nella diagnosi differenziale degli aborti ricorrenti, l’infezione da Listeria monocytogenes sembra essere responsabile di meno del 2% degli aborti.
La listeriosi neonatale può essere classificata con gli stessi criteri utilizzati per l’infezione da streptococco di gruppo B, cioè in una forma precoce evidente nella prima settimana di vita e in una forma tardiva che si sviluppa successivamente.
I bambini possono essere già sintomatici alla nascita: la maggior parte di quelli con infezione a esordio precoce lo diventa entro il secondo giorno di vita.
L’aspirazione di liquido amniotico infetto contribuisce alla patogenesi.
La malattia a esordio precoce può comprendere setticemia, distress respiratorio, lesioni cutanee e la sindrome denominata granulomatosi settica, caratterizzata da ascessi disseminati che interessano il fegato, la milza, le ghiandole surrenali, il polmone e altri organi.
I neonati con malattia a esordio tardivo sviluppano meningite più facilmente di quelli con malattia precoce.
Mentre quest’ultima si verifica spesso in associazione con complicanze ostetriche quali parto prematuro e corioamnionite, la malattia a esordio tardivo interessa tipicamente neonati a termine nati da parto eutocico.
I neonati potrebbero essersi contagiati nel passaggio attraverso il canale del parto ma la patogenesi di questa malattia non è ancora stata definita con esattezza.
La listeriosi non associata alla gravidanza si verifica generalmente in soggetti immunodepressi, sebbene la malattia invasiva possa interessare anche adulti immunocompetenti e particolarmente gli anziani.
I dati ricavati da uno studio multicentrico sulla listeriosi hanno evidenziato che le condizioni predisponenti più comuni riscontrate negli adulti, esclusa la gravidanza, sono la terapia cronica con glucocorticoidi, la presenza di neoplasie maligne, il diabete mellito, le epatopatie, le nefropatie e l’AIDS.
Anche se l’incidenza della listeriosi nei pazienti infettati da HIV è molto più elevata di quella della popolazione generale, essa rappresenta un’infezione opportunistica relativamente rara in corso di AIDS.
Setticemia
Studi clinici hanno dimostrato che l’infezione setticemica senza un focolaio evidente costituisce la più comune manifestazione clinica della listeriosi nei pazienti immunocompromessi, mentre le infezioni del sistema nervoso centrale sono seconde per frequenza.
La setticemia da Listeria non può essere distinta sul piano clinico da quella sostenuta da altri microrganismi.
I pazienti sono generalmente febbrili, spesso in condizioni gravi e possono presentare sintomi prodromici quali mialgie, nausea, vomito e diarrea.
I pazienti immunocompro-messi affetti da listeriosi tendono a sviluppare meno frequentemente un’infezione del sistema nervoso centrale rispetto agli altri adulti, probabilmente perché in questi pazienti vengono prelevate più spesso emocolture in occasione di episodi febbrili, con maggiore probabilità, pertanto, di identificare batteriemie transitorie da Listeria.
Infezioni del sistema nervoso centrale
La presentazione più comune dell’infezione del sistema nervoso centrale da Listeria monocytogenes è la meningite, che può presentarsi sia in forma acuta che (più raramente) subacuta.
I sintomi d’esordio includono febbre, cefalea e alterazione dello stato di coscienza.
L’esame del liquor mostra generalmente pleiocitosi, iperprotidorrachia e glicorrachia nella norma, sebbene a volte possano essere osservati altri quadri liquorali.
La colorazione di Gram è spesso negativa; la diagnosi si basa sull’isolamento colturale di Listeria monocytogenes.
Nonostante il suo nome, l’infezione da Listeria monocytogenes è raramente associata a monocitosi sia nel liquor sia nel sangue.
Altre manifestazioni dell’infezione del sistema nervoso centrale sono rappresentate dall’encefalite, dalla cerebrite e dagli ascessi cerebrali del tronco encefalico o del midollo spinale.
La rara sindrome della romboencefalite comprende la paralisi asimmetrica dei nervi cranici, l’alterazione dello stato di coscienza, la presenza di segni cerebellari e di deficit motori o sensitivi.
I sintomi di altre infezioni del SNC senza meningite possono includere febbre, atassia, convulsioni, alterazioni della personalità e coma.
La rigidità nucale è rara nelle forme senza meningite.
La coltura del liquor può essere negativa, ma le emocolture sono generalmente diagnostiche.
Endocardite
Come la maggior parte delle endocarditi batteriche, l’endocardite da Listeria interessa tipicamente pazienti con valvole protesiche o precedentemente danneggiate.
Il microrganismo ha una predilezione per il cuore sinistro e l’endocardite da Listeria monocytogenes è spesso associata a embolizza-zionc sistemica.
Infezioni focali
Altre infezioni focali che possono verificarsi a seguito di una setticemia non riconosciuta comprendono endoftalmite, peritonite, osteomielite, ascessi viscerali, infezione pleuropolmonare e colecistite.
Lesioni cutanee possono insorgere senza un interessamento sistemico e sono state descritte nei veterinari e negli allevatori di polli.
Recidive
L’infezione ricorrente da Listeria monocytogenes è rara.
Molte recidive sono dovute allo stesso sottotipo responsabile dell’infezione iniziale, il che suggerisce che esse siano legate a un insufficiente trattamento del focolaio di infezione primitiva o a una ripetuta esposizione a una sorgente persistentemente contaminata.
Malattia gastrointestinale
Diverse epidemie di gastroenterite acuta con fonte di infezione comune suggeriscono che Listeria monocytogenes possa provocare una sindrome diarroica acuta in persone che non presentano immunocompromissione.
L’importanza di Listeria monocytogenes nella malattia diarroica sporadica non è chiara.
Anche se il microrganismo non viene identificato mediante i metodi colturali utilizzati di routine per i campioni di feci, alcuni studi condotti valutando campioni di feci provenienti da pazienti ospedalizzati con diarrea acuta mediante l’utilizzazione di terreni selettivi di arricchimento indicano che Listeria monocytogenes non è una causa rilevante di diarrea sporadica.
DIAGNOSI
La diagnosi di listeriosi invasiva si basa sull’isolamento del microrganismo da sedi normalmente sterili, quali il sangue, il liquor o il liquido amniotico.
Il microrganismo cresce con rapidità entro 36 ore sui comuni terreni di coltura, ma dal momento che esistono somiglianze morfologiche tra Listeria e difteroidi e streptococchi sono necessari test biochimici per identificare le specie.
I test sierologici con sospensione dei batteri non sono utili per la diagnosi di listcriosi in quanto l’esposizione al microrganismo (e quindi la presenza di anticorpi) può essere frequente e gli individui infetti possono non mostrare titoli anticorpali elevati a seguito dell’infezione.
I test per gli anticorpi contro la lisleriolisina O sono stati usali nelle indagini epidemiologiche e retrospettivamente nella diagnosi di infezioni del SNC a coltura negativa.
Anche l’isolamento del microrganismo da sedi non sterili, come la vagina e il retto, non è utile per la diagnosi, giacché circa il 5% dei soggetti sani può essere portatore del microrganismo.
La diagnosi differenziale del parto prematuro, dell’aborto spontaneo o della nascita di un feto morto comprende malattie infettive come l’infezione da streptococchi di gruppo B, la sifilide congenita e la toxoplasmosi.
L’infezione da Listeria deve essere sempre considerata nella diagnosi differenziale della meningite nei soggetti immunosoppressi, specialmente nei soggetti sottoposti a trapianto d’organo e nei pazienti che assumono glucocorticoidi, così come nei pazienti con neoplasie ematologiche o infezione da HIV.
Raccomandazioni dietetiche per la prevenzione della listeriosi
Raccomandazioni generali:
- Cuocere bene tutti gli alimenti crudi di origine animale (manzo, maiale e pollo)
- Lavare bene le verdure crude prima di mangiarle
- Conservare gli alimenti non cotti separati dalle verdure, dai cibi cotti e da quelli preconfezionati
- Evitare il latte non pastorizzato e gli alimenti derivati dal latte crudo
- Lavare le mani, i coltelli e i piani d’appoggio dopo aver maneggiato cibi crudi
Raccomandazioni aggiuntive per i soggetti ad alto rischio:
- Evitare i formaggi molli come quelli di tipo messicano, la feta, il brie, il camembert e il gorgonzola. Non è necessario evitare formaggi stagionati, quelli freschi, il burro, la ricotta e lo yogurt
- Cibi avanzati o precotti come gli hot dog dovrebbero essere accuratamente riscaldati prima di essere consumati
- Anche se il rischio di listeriosi associato ad alimenti di gastronomia da banco è relativamente basso e scarsamente definito, le donne gravide e i soggetti immunodepressi dovrebbero evitare questi cibi o sottoporli a nuova cottura prima di consumarli
seconda settimana di vita.
Terapia della Listeriosi
Il trattamento d’elezione della listeriosi consiste nella somministrazione di penicillina o ampicillina per via endovenosa, spesso in associazione con un aminoglicoside per sfruttare l’effetto sinergico.
Il trimetoprim-sulfametoxazolo è stato utilizzato con successo nei pazienti allergici alla penicillina.
In vitro, Listeria monocytogenes risulta sensibile alla penicillina G, all’ampicillina, all’eritromicina, al trimetoprim-sulfametoxazolo, al cloramfenicolo, alla rifampicina, alle tetracicline, agli aminoglicosidi e all’imipenem.
Il cloramfenicolo e la rifampicina, tuttavia, possono antagonizzarc l’effetto battericida delle penicilline.
Poiché Listeria monocytogenes non è sensibile alle cefalosporine, questi agenti non dovrebbero essere utilizzati da soli nel trattamento empirico della setticemia neonatale, della meningite dei neonati o negli ospiti immunocompromessi.
Per gli adulti non in gravidanza affetti da listeriosi, la terapia di scelta è l’ampicillina (12 g/die e.v. in sei dosi) o la penicillina G (da 15 a 20 milioni di unità/die e.v. in sei dosi); nei pazienti immunocompromcssi affetti da meningite alcuni specialisti aggiungono la gentamicina (1,3 mg/kg e.v. ogni 8 ore) per sfruttare l’effetto sinergico.
I pazienti allergici alla penicillina possono essere trattati con il trimetoprim-sulfametoxazolo (15/75 mg/kg/die e.v., in tre dosi uguali ogni 8 ore).
La meningite in un paziente immunocompetente può richiedere 2-3 settimane di terapia antibiotica dopo la defervescenza.
La meningite, la setticemia, l’endocardite e la listeriosi non meningea nei pazienti immunocompromcssi devono essere trattate più a lungo, probabilmente per 4-6 settimane.
La listeriosi neonatale può essere trattata con un ciclo di 2 settimane di ampicillina.
Ai bambini che pesano meno di 2 kg devono essere somministrati 100 mg/kg/die di questo antibiotico, divisi in due dosi uguali, durante la prima settimana di vita e 150 mg/kg/die durante la seconda settimana di vita.
I bambini che pesano più di 2 kg devono ricevere 150 mg/kg/die di ampicillina, divisi in tre dosi uguali, durante la prima settimana di vita e 200 mg/kg/die durante la seconda settimana di vita.
L’aggiunta di un aminoglicoside va considerata per l’infezione neonatale (gentamicina, 5 mg/kg/die, in due dosi, durante la prima settimana di vita: 7.5 mg/kg/die, in tre dosi uguali, durante la seconda settimana).
Per la listeriosi nelle donne in gravidanza è raccomandato un ciclo di 2 settimane di ampicillina (4-6 g/die in quattro dosi uguali).
Durante l’ultimo mese di gravidanza le donne infette con grave allergia alla penicillina possono essere trattate con l’eritromicina.
Prognosi della Listeriosi
II trattamento della setticemia materna in gravidanza può prevenire l’infezione neonatale.
La terapia antibiotica del neonato può limitare le sequele, anche se la granulomatosi settica, ampiamente disseminata, risulta frequentemente fatale nonostante il trattamento.
La forma a esordio precoce è gravata da un più alto lasso di letalità rispetto a quella a esordio tardivo, e la listeriosi che colpisce ospiti immunocompromcssi ha una prognosi peggiore rispetto a quella che si verifica in adulti sani.
Prevenzione
Listeria monocytogenes si isola frequentemente dagli alimenti; negli Stati Uniti la Food and Drug Administration, l’U.S. Department of Agricolture e i produttori stanno attivamente cercando di definire ulteriori misure atte a ridurre la contaminazione da Listeria monocytogenes dei cibi sottoposti a processi listericidi.
La prevenzione della listeriosi richiede, nelle persone a più alto rischio, il rispetto di regole dietetiche che devono essere prescritte dal medico.
Non è necessaria la profilassi per i contatti di pazienti con listeriosi. I medici devono essere esortati a segnalare i casi di listeriosi alle autorità locali o nazionali.
La segnalazione dei casi e la sottotipizzazione degli isolati clinici posono facilitare il precoce riconoscimento delle epidemie e la prevenzione di casi successivi.
BIBLIOGRAFIA
Lorber B: Listeriosis. Clin Infect Dis 24:1. 1997
Pinner RW et al: Role of foods in sporadic listeriosis: II. Microbiologie and epidemiologie investigation. JAMA 267:2046, 1992
Rysf.R ET. Marth EH (eds): Listcria, Listeriosis, and Food Safety. 2d ed. New York. Marcel Dekker. 1999
Schlech WF et al: Epidemie listeriosis—cvidence l’or transmission by food. N Engl J Med 308:203, 1983
Schuchat A et al: Role of foods in sporadic listcriosis: 1. Case-control study of die-tary risk factors. JAMA 267:2041. 1992
